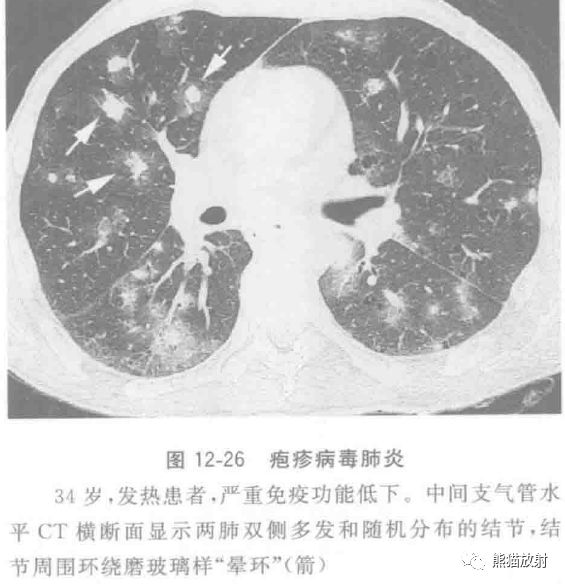
图片

图文并茂︱常见病毒性肺炎的影像学特征
2025年2月2日
病毒性肺炎的临床症状和体征无特征性,感染的临床病程与患者的整体免疫状态高度相关。急性细支气管炎这一术语常用来描述婴儿及儿童的以急性喘息为特征的呼吸道病毒感染。病毒感染可导致多种形式的下呼吸道疾病,包括气管支气管炎、细支气管炎,以及常见的双侧肺炎。病毒感染者易继发细菌性肺炎。机化性肺炎为非特异性的修复反应,可由多种原因及潜在的病理过程导致,包括病毒感染。就普通人群的发病率及病死率而言,甲型流感病毒是最重要的呼吸道病毒。它通过气溶胶或呼吸道飞沫以人传人的方式传播。近年来,流感及副流感病毒被认为是免疫抑制患者包括实体器官移植受者呼吸道疾病的重要致病因素。高分辨CT的主要表现为两肺广泛分布的磨玻璃致密影、实变、小叶中心结节和分枝状线状影。5%~10%的婴儿和儿童的急性呼吸道感染是腺病毒感染所致,成人呼吸道腺病毒感染不到1%。Swyer-James-MacLeod综合征被认为是继发于儿童腺病毒感染的感染后闭塞性细支气管炎(BO)。感染后闭塞性细支气管炎的CT表现为肺野内边界清楚的局灶性密度增高区和密度减低区伴有肺透亮区内血管变细,细支气管管壁增厚和细支气管扩张。呼气相CT常可见到空气潴留,表现为局部边界清楚的透亮区,表明该区域肺组织的通气及灌注较差(图12-22)。腺病毒感染越来越被认为是免疫抑制患者如干细胞或实体器官移植受者肺部感染发病率病死率的重要原因。CT表现为两肺小叶或肺段分布的斑片状实变影,小叶中心结节和分枝状线状影和(或)两肺随机分布的磨玻璃致密影(图12-23)。呼吸道合胞病毒是引起婴儿下呼吸道感染的最常见病毒。儿童严重呼吸道合胞病毒感染的主要危险因素是早产(<36周的妊娠)、先天性心脏病、慢性肺部疾病,免疫抑制状态和多发性先天性异常。CT表现包括小叶中央结节,气腔实变,磨玻璃致密影和细支气管壁增厚(图12-24)。EB病毒的原发感染常发生于年轻时期,表现为传染性单核细胞增多症和典型的三联症——发热、咽炎、淋巴结肿大,常伴有脾大。轻微无症状的肺炎出现在5%~10%的传染性单核细胞增多症的病例。EB病毒性肺炎的CT表现与其他病毒性肺炎类似。水痘-带状疱疹病毒感染常见于儿童,具有传染性,成人感染也日渐增多。临床表现有两种类型:一种为水痘,发生在既往未感染过的个体,并具有传染性;一种为带状疱疹,为潜伏的病毒再次激活,表现为单侧皮肤皮疹。成人感染水痘最严重的并发症是肺炎,但较少见。据报道,约每400例成人感染水痘患者中有一例并发水痘肺炎,在孕妇及免疫抑制患者中更常见。薄层CT表现为多发直径为5~10mm的结节灶(图12-25),部分结节周围有磨玻璃样晕环,斑片状磨玻璃影和聚集的结节。偶见病变钙化,表现为边界清楚,散在分布的直径2~3mm的致密钙化结节。单纯疱疹病毒1型肺炎是一种可能危及生命的感染,几乎仅见于免疫功能低下和(或)机械通气的患者,通常是多种微生物感染中的一部分。CT表现包括斑片状肺叶、段或亚段性的实变影和磨玻璃状致密影;伴小叶中央结节及树芽征,后者也见于单纯疱疹病毒2型感染患者;结节周围也可环绕磨玻璃样“晕环”(图12-26)。1993年春天,在美国西南部的健康成年人中出现一种啮齿动物源性人畜共患疾病,其特点是严重的急性呼吸衰竭,临床进展迅速及高病死率。汉坦病毒感染引起的弥漫性气腔病变,称为汉坦病毒肺综合征(HPS)。接受治疗的患者死亡率达35%。组织学上特征性改变为弥漫性肺泡损伤,分为渗出期和增殖期。影像表现初期可以正常,但逐步恶化,呈现肺水肿和急性呼吸窘迫综合征的征象(图12-27)。胸部X线平片表现反映HPS和急性呼吸窘迫综合征(ARDS)肺泡上皮损伤的程度。当接受造血干细胞(HSC)和实体器官移植的患者及艾滋病患者的CD4细胞减少到10/L以下时,巨细胞病毒性肺炎是这类患者发病和致死的主要原因。巨细胞病毒感染在骨髓移植(BMT)接受者中高达70%,而且大约1/3会进展为CMV肺炎。这种并发症特征性地发生于移植术后(移植后30~100天),中位发病时间为移植术后50~60天。巨细胞病毒肺炎的CT特点包括肺叶实变,弥漫性和局灶性磨玻璃影,不规则网状影和多发粟粒样结节或小结节,伴周围磨玻璃样影(“晕征”)(图12-28)。人类偏肺病毒是种最近发现的RNA病毒,属于偏肺病毒。通常与急性呼吸道感染相关,包括上呼吸道感染,下呼吸道支气管炎和细支气管炎,流感样综合征和肺炎。CT表现包括两肺不对称分布的斑片状磨玻璃样影,小结节影和多灶性的实变(图12-29)。偏肺病毒性肺炎感染的过程中,肺实质受累可能会导致肺间质性病变和纤维化。引起严重急性呼吸系统综合征(SARS)的相关冠状病毒( SARS-COV)是一种临床表现为进展性肺炎的系统性感染。在出现症状后10天内死亡的患者中发现组织学上最显著的特点是急性弥漫性肺泡损伤导致气腔水肿。SARS-COV感染的影像学特征包括单侧或双侧的磨玻璃状致密影,单侧或双侧的局灶性实变,或是两种表现的混合。在磨玻璃状影中可见小叶间质或小叶间隔增厚(图12-30)。禽流感是由A型流感病毒的H5N1亚型引起的。大部分人类感染由密切接触受感染的鸟类所致,通常是家禽或其分泌物。H3N1感染的总体病死率超过60%。大多数患者就诊时胸部X线片已经出现异常,最常见的影像学表现是多灶性实变。CT最常表现为局灶性、多灶性或弥漫性的磨玻璃影或实变影。也常见假空洞、肺大泡、淋巴结肿大和小叶中心结节。2009年春天暴发了一种与新型猪源性流感病毒A(H1N1)密切相关的重症肺炎。2009年6月11日,世界卫生组织宣布21世纪第一场流行病是由猪源性流感病毒A(H1N1)引起的。如今,病毒继续在全球范围内传播,人类间传播率似乎很高,但其毒力并不高于季节性流感。该疾病蔓延迅速,截至2009年9月7日,已记录在案的全球254206病例中有2837例患者死亡。主要的CT表现为单或双侧磨玻璃影,伴或不伴局灶性或多灶性实变。CT表现磨玻璃影和实变影主要分布于支气管血管周围和胸膜下,类似机化性肺炎(图12-31)。也可见多灶性空气潴留(图12-32)。